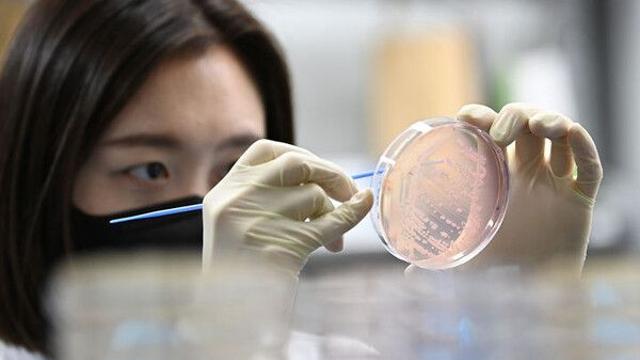
thumbimg

⚡ 뉴스 pick
- 씨엔씨 푸른병원, 잔반 ZERO 챌린지로 탄소중립 실천
- 2025.10.16 [메디먼트뉴스]
- 유영하 “MBK, 약탈적 헤지펀드”…유동수 “홈플러스 파산 불가피”
- 2025.10.16 [경기일보]
- 전현무 “형이 왜 거기서 나와”…설민석, ‘전현무계획3’ 첫 회 등판
- 2025.10.16 [일간스포츠]
- 타이어 불균형 마모, 그냥 두면 큰돈 든다… 원인과 예방법
- 2025.10.16 [더드라이브]
- AI 친구와 영어 배우는 ‘알레프 랩’, 美 와이콤비네이터 투자 유치
- 2025.10.16 [이데일리]
- 롯데월드, '지속가능한 글로벌 엔터테인먼트 기업'으로
- 2025.10.16 [일간스포츠]
- 빅토리아 시크릿 쇼 역사상 첫 런웨이 퍼포먼스 끝낸 트와이스
- 2025.10.16 [엘르]
- '17일 개막' 제106회 전국체육대회 열전 1주일 돌입
- 2025.10.16 [한라일보]
- 김건희 학술지 논문, 위조·표절 의혹 제기 3년 만에 학회 검증 돌입
- 2025.10.16 [모두서치]
- 주북中대사, 北경공업전시회 찾아 "교류·협력 강화" 기대
- 2025.10.16 [모두서치]
- 유튜브·유튜브 뮤직 서비스 장애…구글 "불편 드려 죄송"(종합)
- 2025.10.16 [모두서치]
- 유철환 권익위원장, 청렴도 지적에 "송구하고 드릴 말씀 없어…시정하겠다"
- 2025.10.16 [모두서치]
- 비 많은 10월, 식품 곰팡이 주의…"가열해도 독소는 남아"
- 2025.10.16 [모두서치]
- `英 명문대 박사` 학력 위조 교수, 항소심서 징역 10월
- 2025.10.16 [이데일리]
- “기대도 안 했는데”…상생페이백 환급에 사용처 추천도 속속
- 2025.10.16 [이데일리]
- 유튜브, 전 세계 영상 재생 장애 복구… 원인 ‘미공개’
- 2025.10.16 [이데일리]
- 에스파 윈터, 보석보다 빛나는 순백의 아름다움
- 2025.10.16 [일간스포츠]
- “억울해” 빽가, 나라땅 무단 사용 의혹에 입 열었다
- 2025.10.16 [스포츠동아]
- 장평순 교원그룹 회장 "요람에서 무덤까지, 교육을 넘어 삶의 제국으로"
- 2025.10.16 [CEONEWS]
- 서울시, 도시재정비위원회 경관 변경 심의 간소화
- 2025.10.16 [모두서치]